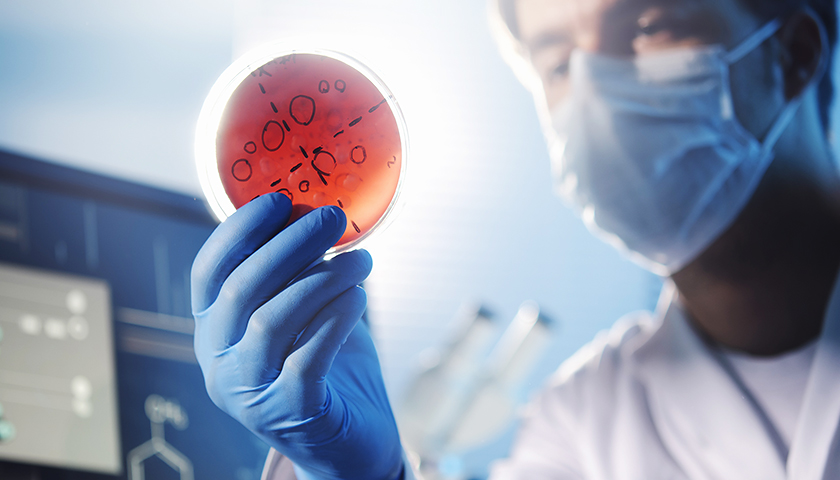
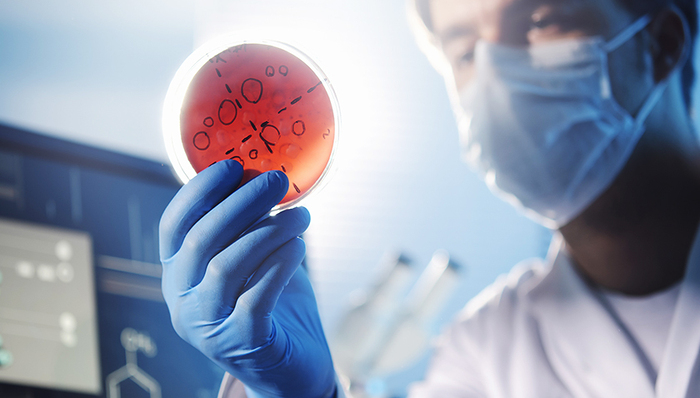
高承勇,警方抓获,侦破工作,连环杀人案,犯罪嫌疑人,关键信息,白银区,白银市,警方透露,父系遗传

在甘肃省白银市,从1988年至2002年的14年间,先后发生了9起女性惨遭入室杀害的案件,凶手专挑红衣女性下手,作案手段残忍。今年8月26日,甘肃警方在白银市工业学校一小卖部内将犯罪嫌疑人高承勇抓获。这起笼罩了白银市28年之久的命案终于宣告侦破。
警方对犯罪嫌疑人的审讯工作仍在继续,央视记者也在甘肃白银探寻有关这起案件的蛛丝马迹。
甘肃白银14年内发生9起恶性强奸杀人案
经过警方的初步审查,犯罪嫌疑人高承勇对所犯罪行供认不讳。
1988年至2002年,甘肃省白银市白银区先后发生9起强奸残害女性的系列杀人案件。其间,内蒙古自治区包头市昆都仑区也发生过类似案件。犯罪分子采取残忍手段强奸、杀害女性,受害人中年龄最小的仅仅8岁,社会影响极其恶劣。
第一起案件:1988年的5月26日下午5点多,白银市23岁的女职工白某被害于白银区的家中;
第二起案件:1994年7月27日下午2点50分左右,白银市供电局19岁的员工石某在其宿舍遇害;
第三起案件:1998年1月16日下午4点多,白银区胜利街29岁的女青年杨某在家中遇害;
第四起案件:1998年1月19日下午5点45分左右,家住白银区水川路的27岁女青年邓某在家中遇害;
第五起案件:1998年7月30日下午6点多,白银供电局职工曾某8岁的女儿苗苗(化名)在家中遇害;
第六起案件:1998年11月30日上午11点左右,白银某公司女青年崔某在白银区东山路的家中被杀害;
第七起案件:2000年11月20日上午11点多,白银棉纺厂28岁的女工罗某在家中被杀害;
第八起案件:2001年5月22日上午9点左右,白银区妇幼保健站28岁女护士张某在其水川路的家中被害;
第九起案件:2002年2月9日,25岁的女子朱某在白银区一宾馆客房内被害。


这一系列恶性强奸杀人案发生后,公安机关高度重视,2001年8月,此案被公安部列为督办案件。尽管各级公安机关全力侦破此案,但案件迟迟没有取得实质性突破。
嫌疑人落网 对11起犯罪事实供认不讳
2016年3月,公安部刑侦局组织开展疑难命案积案攻坚行动,对发生在甘肃和内蒙古的系列强奸杀人残害女性案展开新一轮侦破工作。专家组确定了利用新科技手段对原有生物物证再利用的主攻方向,取得重大突破。8月26日,犯罪嫌疑人高承勇在白银市工业学校的一个小卖部内落网。
犯罪嫌疑人高承勇经营了一家名为“白银市工业学校学生服务部”的小卖部,位于学校食堂一侧。小卖部的外观朴素陈旧,透过窗户,记者得以看到40平米左右的小卖部分为工作区和生活区两部分,工作区货架上摆放着文具和小吃等商品,生活区内则摆放着一张双人床,窗台上还有洗漱用品。
高承勇现年52岁,被警方抓获后他对自己在白银、包头两地作案11起、杀死11人的犯罪事实供认不讳。
锁定嫌疑人 DNA-Y染色体成关键
据了解,在28年这么长的时间之后,在茫茫人海之中能锁定犯罪嫌疑人高承勇,DNA-Y染色体成破案的关键。
中国人民公安大学侦查与反恐怖学院院长陈刚介绍:“DNA存在于每一个细胞核里,在白银系列案件中,警方提取了他的精斑,这也是他的体液,体液里面有细胞和细胞核,因此可以提取DNA进行检验。”

DNA-Y染色体又是什么?陈刚介绍,DNA-Y染色体实际上是一种父系遗传的基因,DNA-Y染色体是父系一代代传下来的,从DNA-Y染色体可以圈定一个家族族谱范围。
据了解,此案中首先是高承勇家族中某一个人被外地警方抓获后,在比对基因时发现此人的基因与犯罪现场所提取到的基因相似度很高,办案机关在海量的数据信息之中找到了高承勇相关的关键信息,提取了他的指纹和DNA与当年命案现场留下的指纹和DNA进行信息比对,就此确定了他的嫌疑人身份。
嫌犯的两个儿子是大学生 村民称其“混得好”
户籍信息显示,犯罪嫌疑人高承勇1964年11月10日生,甘肃榆中县人,高中毕业,已婚。其户籍所在地为兰州市榆中县,和白银市白银区水川镇隔黄河而望。
据榆中县青城镇虽然属于兰州,但是离白银较近,所以当地人出外打工第一选择往往是白银。破案之前,在当地百姓眼中,高承勇就是许多出外打工人员中的一员,而且是“混”得不错的一员。
这些年,高承勇过着隐秘的生活。警方透露,持续作案那十几年,高承勇就居住在老家,每次作案就从榆中县到白银市区,作完案回家继续生活。2002年作完最后一起案件后,高承勇开始在外打工,后在白银郊区租了房子。
破案之后,该村数位村民都表示,“高承勇竟然是个变态杀人嫌犯”的消息已在村子里传开,许多村民对此消息都持怀疑态度。让许多村民羡慕的是,高承勇的两个儿子自小学习优异,都是大学本科毕业,如今都已参加工作。高承勇一直在白银打工,妻子在娘家靖远打工,逢年过节,高承勇大多会回家,有时候还是开着小汽车回来的。
接受记者采访 高承勇请求捐献器官
在央视记者第一次采访到犯罪嫌疑人高承勇时,高承勇有一个请求:捐献自己的器官。对此陈刚分析,因为年龄不同,犯罪嫌疑人的心理可能会有一些变化,“可能年纪大了之后,会反思、会有良心发现”。
另外,陈刚还认为,犯罪嫌疑人可能知道自己罪不可赦,想在死之前挽回一点,给公众稍微留点好印象。
甘肃白银系列强奸杀人残害女性案告破,消除了当地的一大社会隐患,也让受害者家属和当地民众有所宽慰。犯罪嫌疑人高承勇为什么会对这么多女性痛下杀手?他有着怎样的心理和性格?这些问题也许只有伴随着调查进一步深入才会有答案。杀害11人且其中一名是8岁幼女,高承勇的凶残程度令人发指,等待他的除了舆论唾弃,还有法律的严厉制裁。真凶难逃审判,正义不会缺席。

评论